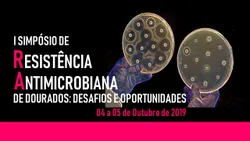

{{'Label_VerifiqueOSeuEmail' | translate}}
{{'Label_EnviamosUmEmailComLinkDeVerificacaoPara' | translate}} {{credencial.email}}. {{'Label_AssimQueChegarTeraValidadeDe10Minutos' | translate}}

{{'Label_EnviamosUmEmailComLinkDeVerificacaoPara' | translate}} {{credencial.email}}. {{'Label_AssimQueChegarTeraValidadeDe10Minutos' | translate}}